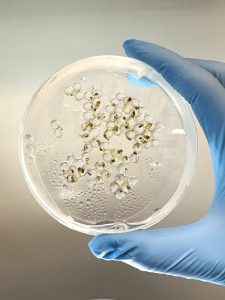

Foray Announces First Fabricated Seed Partnership with West Coast Chestnut
CAMBRIDGE, Mass.–(BUSINESS WIRE)–Foray Bioscience, a plant biomanufacturing company growing plant products from the cell up, today announced its first seed partnership with West Coast Chestnut, a leading tissue culture chestnut nursery. The partnership follows the validation of Foray’s “fabricated seed” products – enabling scalable propagation from single cells, accelerating the path to market for new plant varieties. Fabricated seeds are encapsulated plant embryos grown directly from plant cells that can be sown like a conventional seed to produce a whole plant.
This announcement marks Foray’s first fabricated seed commercialization partnership and underscores growing demand for accelerated plant propagation technologies. Under the agreement, Foray will develop fabricated seeds for select chestnut varieties, aiming to shave years off of time to market with rapid bulking and abbreviated acclimatization steps that hold back traditional propagation. The agreement outlines a multi-year forward purchase agreement for fabricated seeds of regionally-important chestnut cultivars. It also establishes West Coast Chestnut as a key partner in validating additional fabricated seed products for reforestation in the Pacific Northwest.
Foray’s “fabricated seed” products enable scalable propagation from single cells, accelerating the path to market for new plant varieties.
“We’re excited to work with Foray to explore a new way of scaling chestnut propagation,” said Sawyer Clark, of West Coast Chestnut. “We’ve spent years working a number of chestnut cultivars into tissue culture and then growing them to be ready for growers. However, the process of propagation of each cultivar is slow, and capital intensive. Fabricated seeds have the potential to unlock a new propagation pathway that is faster, more predictable, and designed to scale.”
West Coast Chestnut brings experience in tissue culture propagation, orchard development, and tree crop farming, making the organization a well-positioned early partner to pilot Foray’s fabricated seed technology.
“This work represents a shift in how plants can be scaled,” said Dr. Ashley Beckwith, Founder & CEO of Foray Bioscience. “By combining plant cell culture, AI-directed experimentation, and fabricated seed technology into a single platform, we’re turning propagation into a predictable, repeatable process. This approach is designed to unlock reliable supply for many plant species where consistency and scale have historically been out of reach.”
The contract builds on Foray’s broader platform strategy, which pairs physical bioproduction capabilities with its AI-enabled R&D software, Pando. Together, these systems allow Foray to systematically develop, optimize, and reproduce plant growth processes across species and use cases.
About Foray Bioscience
Foray makes it possible to build any plant product from a single cell. Using plant cell culture, AI-driven R&D tools, and scalable production systems, Foray makes plant growth controllable from the single cell. The company partners across forestry, agriculture, and natural products to build lasting access to plants and plant products by redefining the way we grow.
About West Coast Chestnut
West Coast Chestnut is a family-owned and operated farm and chestnut nursery based in Oregon’s Willamette Valley, with more than 30 years of experience growing perennial crops including chestnuts, hazelnuts, and blueberries. The company focuses on propagating chestnuts for commercial production, regenerative agriculture, and habitat restoration.
